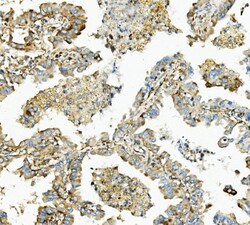
Invitrogen HK1 Monoclonal Antibody (4B7) 100 &mu;g; Unconjugated:Antibodies,

Learn More
Invitrogen™ HK1 Monoclonal Antibody (4B7)


Mouse Monoclonal Antibody
Supplier: Invitrogen™ MA549200
Description
Adding 0.2 mL of distilled water will yield a concentration of 500 μg/mL. Positive Control - WB: human Hela whole cell, human HEK293 whole cell, human U-87MG whole cell, human K562 whole cell, human A549 whole cell, rat PC-12 whole cell, mouse NIH/3T3 whole cell. IHC: human lung cancer tissue, human mammary cancer tissue, human testis cancer tissue, mouse intestine tissue, rat intestine tissue IHC-F: human placenta tissue. ICC/IF: U20S cell. Flow: PC-3 cell. Store at -20°C for one year from date of receipt. After reconstitution, at 4°C for one month. It can also be aliquotted and stored frozen at -20°C for six months. Avoid repeated freeze-thaw cycles.
This gene encodes a member of the ARHGAP family of Rho/Rac/Cdc42-like GTPase activating proteins. The encoded protein interacts with the Ras-related protein Gem through its N-terminal domain. Separately, it interacts with RhoA through a RhoGAP domain, and stimulates RhoA-dependent GTPase activity. Alternatively spliced variants that encode different protein isoforms have been described but their full-length nature has not been determined.
Specifications
| HK1 | |
| Monoclonal | |
| 500 μg/mL | |
| PBS with 4mg trehalose and 0.05mg sodium azide | |
| P05708, P17710, P19367 | |
| HK1 | |
| E.coli-derived human Hexokinase 1/HK1 recombinant protein (Position: D17-R323). | |
| 100 μg | |
| Primary | |
| Human, Mouse, Rat | |
| Antibody | |
| IgG2a |
| Flow Cytometry, Immunohistochemistry (Frozen), Immunohistochemistry (Paraffin), Western Blot, Immunocytochemistry | |
| 4B7 | |
| Unconjugated | |
| HK1 | |
| BB404130; brain form hexokinase; dea; downeast anemia; glycolytic enzyme; HEXOKIN; hexokinase; hexokinase 1; hexokinase I; hexokinase IR; hexokinase type I; Hexokinase, tumor isozyme; hexokinase-1; Hexokinase-A; HK; HK I; HK1; Hk-1; Hk1-s; HK1-ta; HK1-tb; HK1-tc; HKD; HKI; HMSNR; HXK1; mHk1-s | |
| Mouse | |
| Antigen affinity chromatography | |
| RUO | |
| 15275, 25058, 3098 | |
| -20°C | |
| Lyophilized |
Your input is important to us. Please complete this form to provide feedback related to the content on this product.